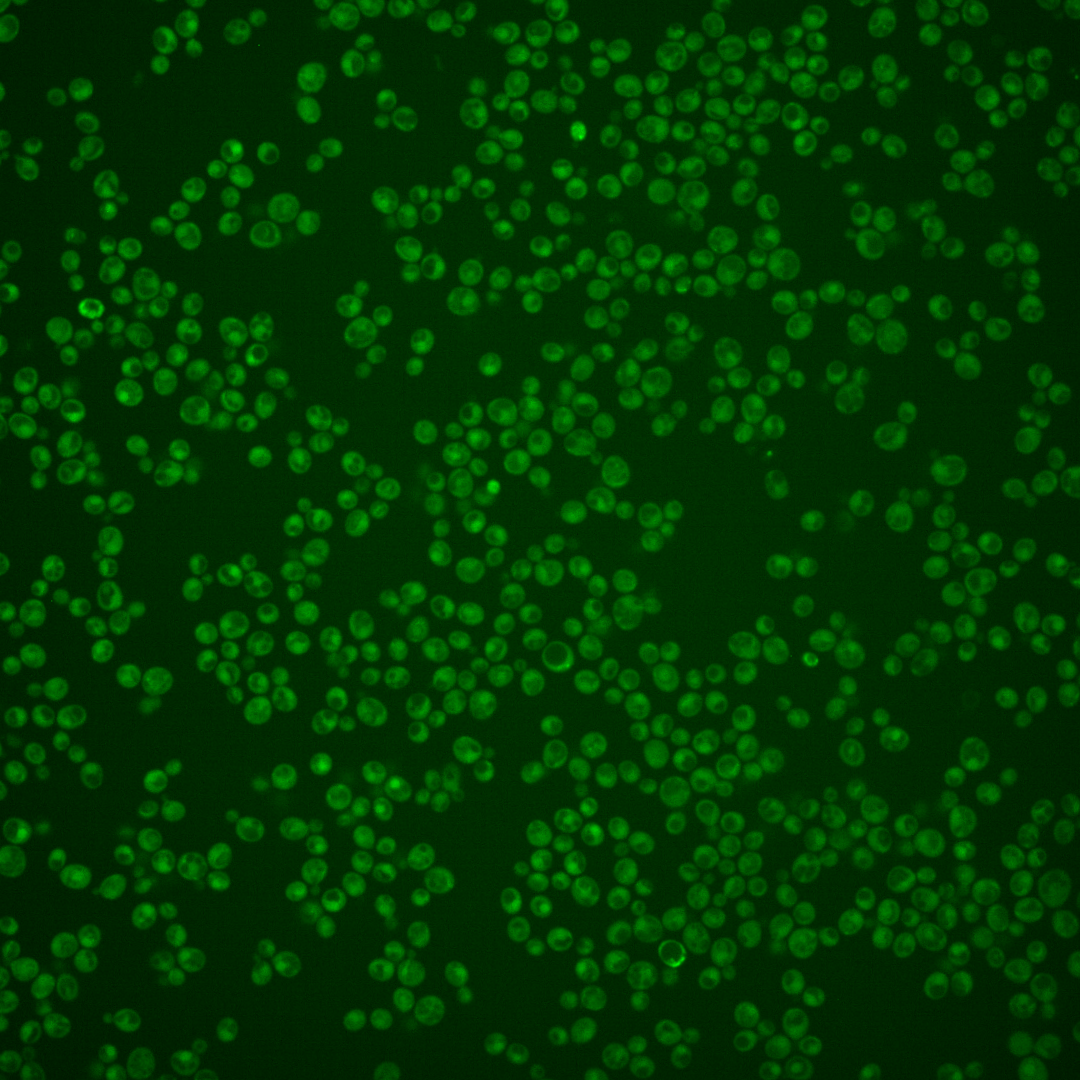
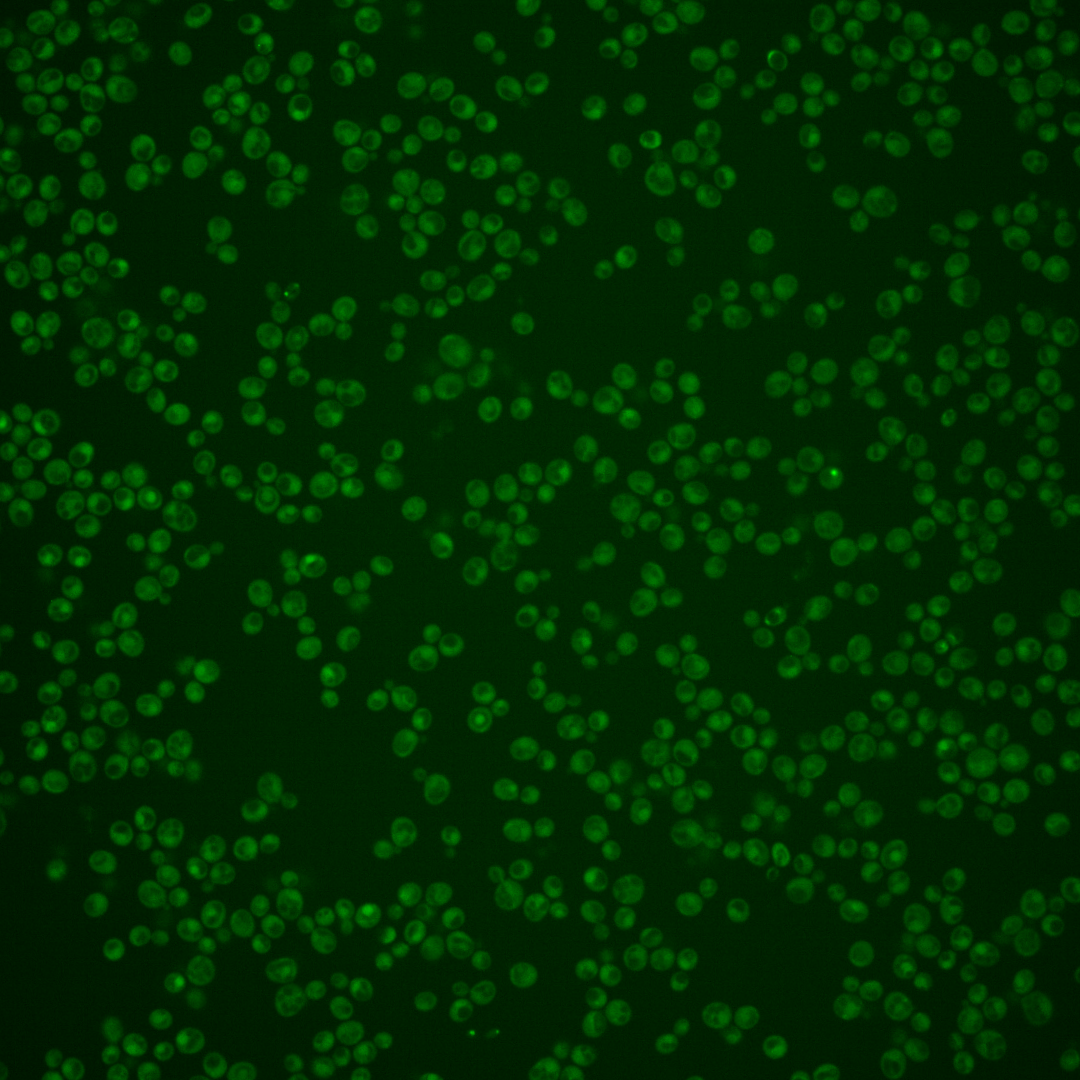
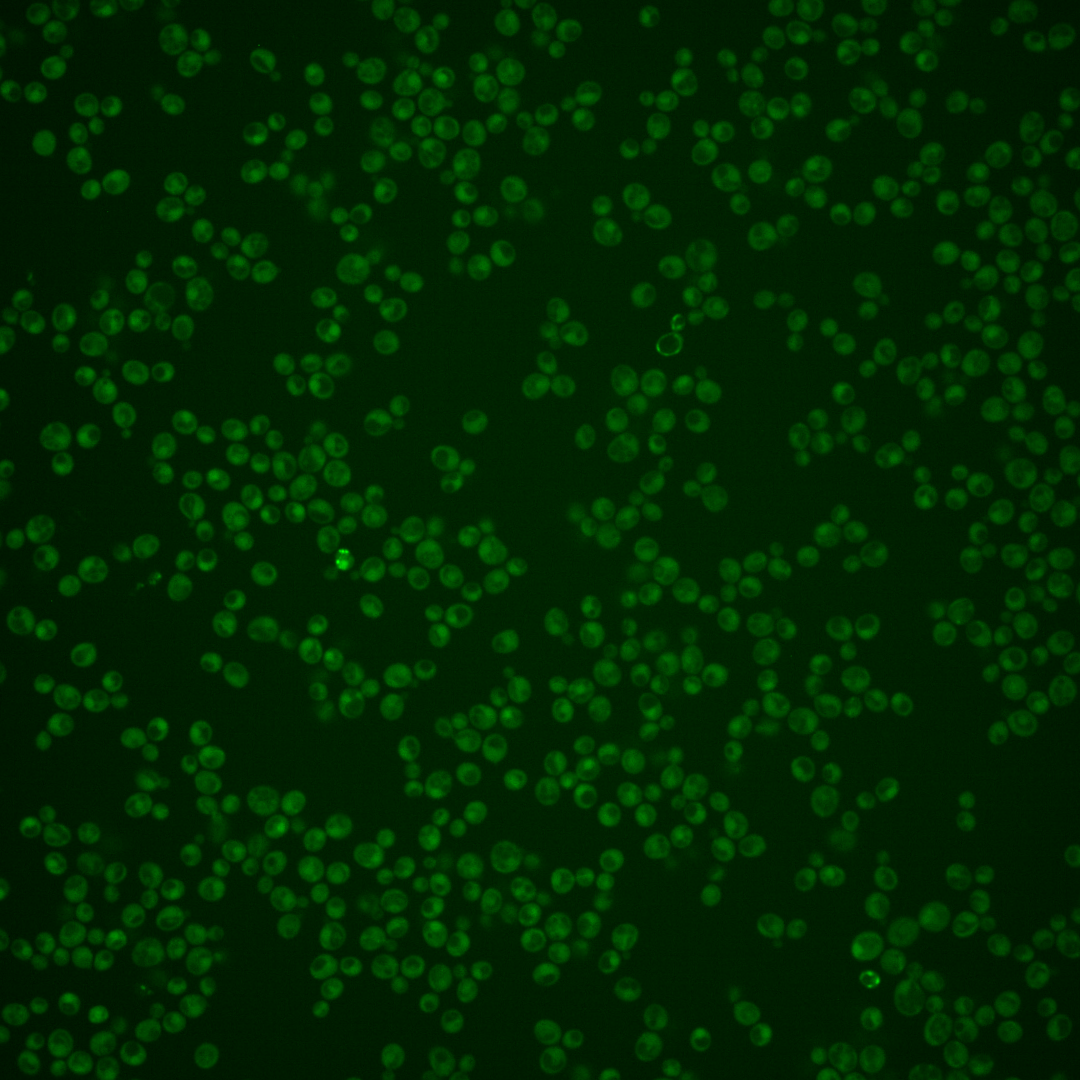
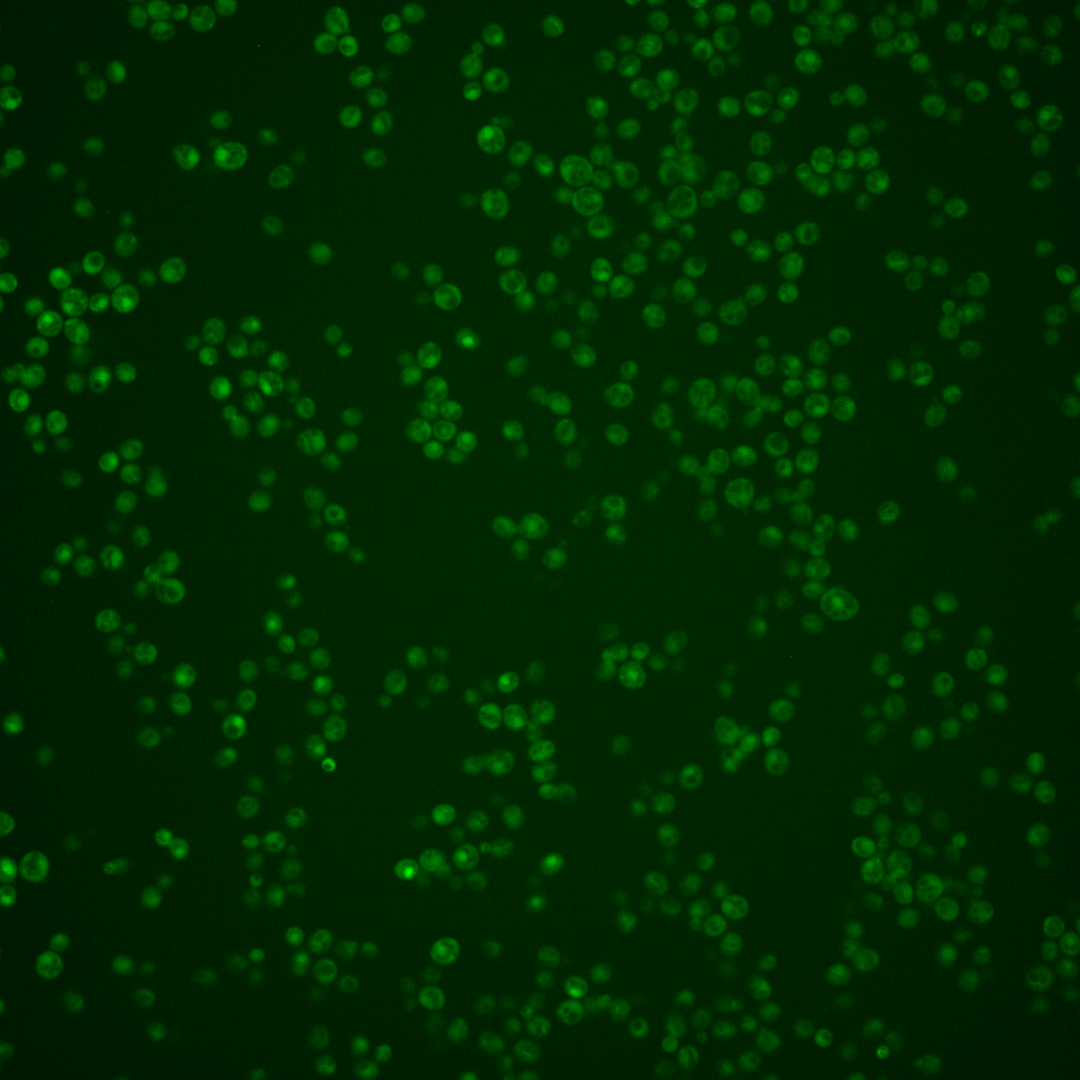
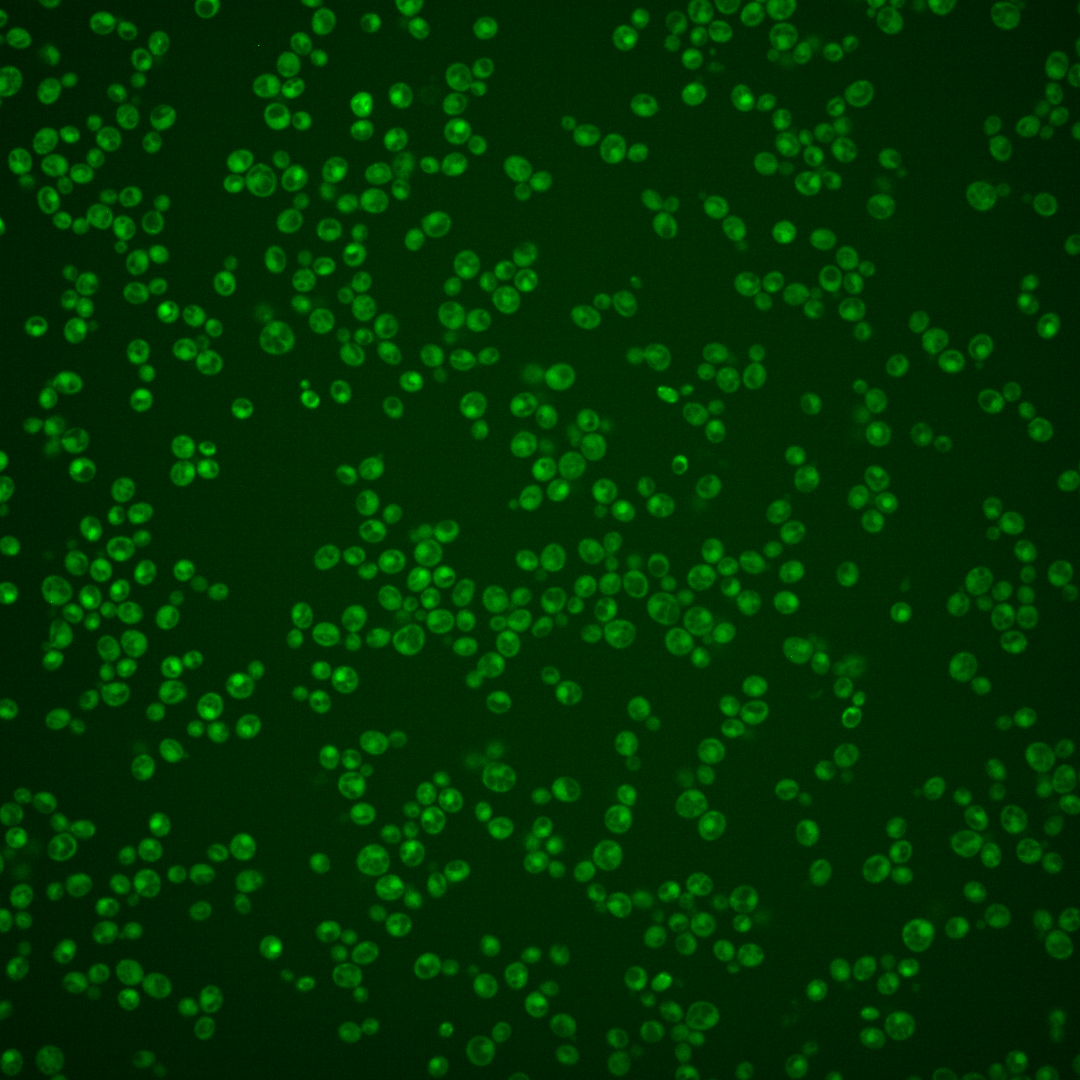
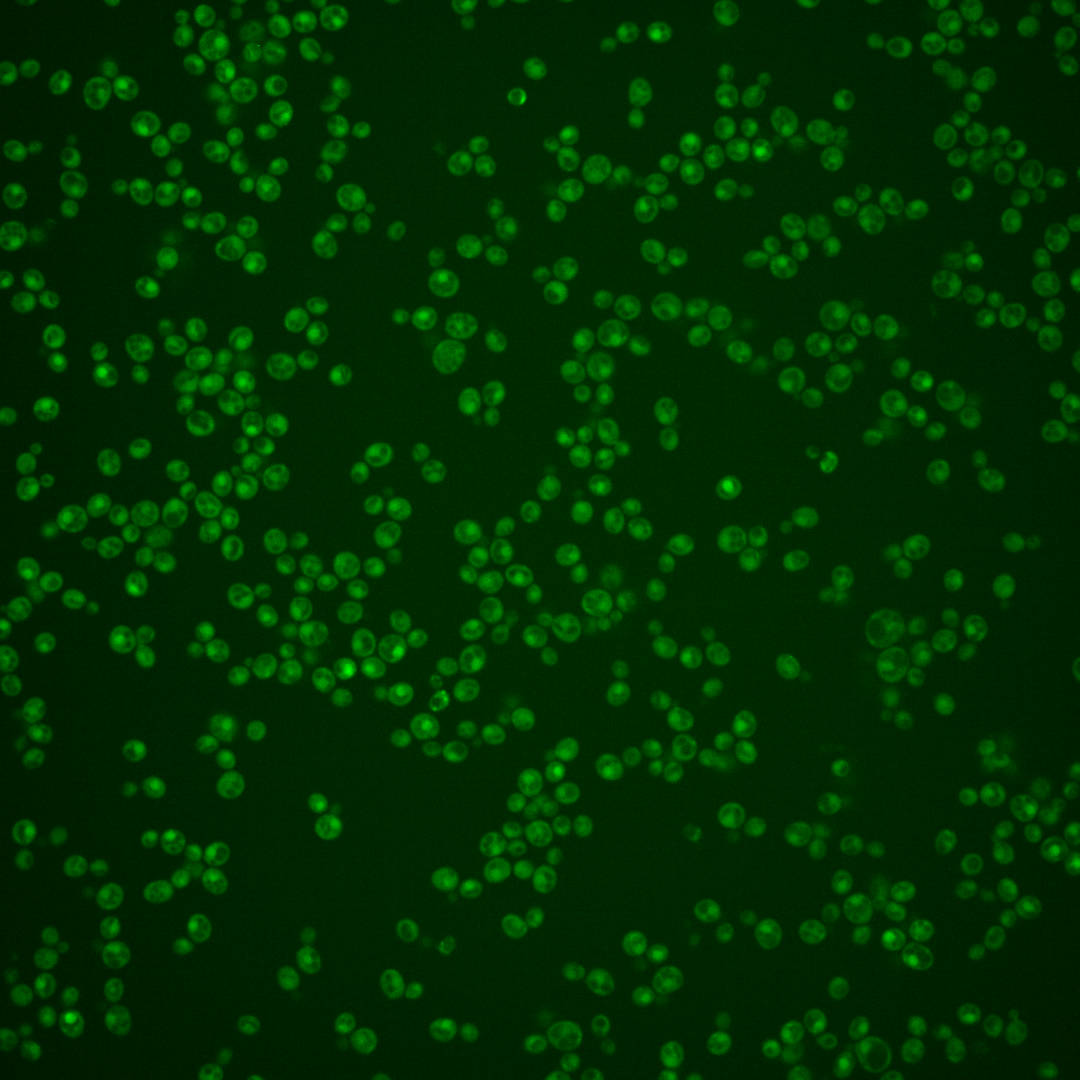
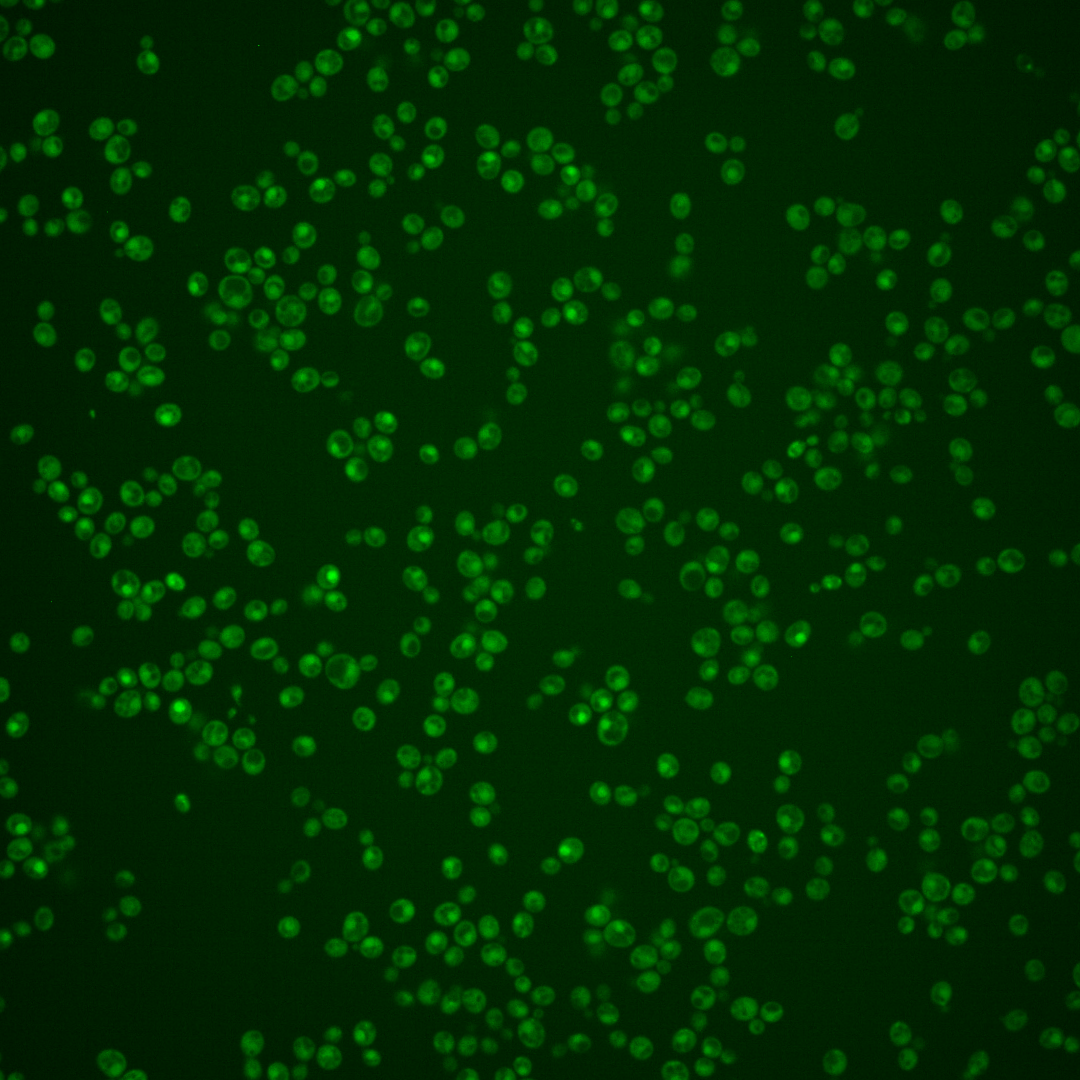

| Standard name | |
|---|---|
| Human Ortholog | |
| Description | CDK inhibitor and nuclear anchor; during the cell cycle Far1p sequesters the GEF Cdc24p in the nucleus; phosphorylation by Cdc28p-Cln results in SCFCdc4 complex-mediated ubiquitin-dependent degradation, releasing Cdc24p for export and activation of GTPase Cdc42p; in response to pheromone, phosphorylation of Far1p by MAPK Fus3p results in association with, and inhibition of Cdc28p-Cln, as well as Msn5p mediated nuclear export of Far1p-Cdc24p, targeting Cdc24p to polarity sites |
Micrographs




















































































Sub-cellular Localization
Yeast GFP Assignment
Protein Abundance
Localization Change
External localization resources
| ensLOC | DeepLoc | |||||||||||||||||||||||
|---|---|---|---|---|---|---|---|---|---|---|---|---|---|---|---|---|---|---|---|---|---|---|---|---|
| Localization | WT1 | WT2 | WT3 | RAP60 | RAP140 | RAP220 | RAP300 | RAP380 | RAP460 | RAP540 | RAP620 | RAP700 | HU80 | HU120 | HU160 | rpd3Δ_1 | rpd3Δ_2 | rpd3Δ_3 | WT1 | WT2 | WT3 | AF100 | AF140 | AF180 |
| Cortical Patches | 0 | 0 | 0 | 0 | 0 | 0 | 0 | 0 | 0 | 0 | 0 | 0 | 0 | 0 | 0 | 1 | 0 | 0 | 3 | 3 | 2 | 9 | 11 | 12 |
| Bud | 0 | 1 | 0 | 0 | 0 | 2 | 3 | 1 | 6 | 5 | 7 | 2 | 3 | 0 | 1 | 0 | 0 | 0 | 24 | 15 | 1 | 20 | 11 | 17 |
| Bud Neck | 0 | 3 | 3 | 0 | 2 | 1 | 3 | 6 | 5 | 3 | 0 | 7 | 0 | 0 | 0 | 1 | 0 | 0 | 5 | 5 | 0 | 8 | 3 | 12 |
| Bud Site | 0 | 0 | 0 | 0 | 0 | 0 | 1 | 0 | 1 | 2 | 3 | 3 | 0 | 0 | 0 | 0 | 0 | 0 | – | – | – | – | – | – |
| Cell Periphery | 1 | 2 | 2 | 1 | 0 | 0 | 0 | 0 | 0 | 0 | 1 | 0 | 1 | 0 | 0 | 0 | 0 | 1 | 1 | 0 | 2 | 1 | 1 | 2 |
| Cytoplasm | 227 | 248 | 126 | 53 | 145 | 81 | 190 | 130 | 122 | 131 | 147 | 124 | 369 | 431 | 549 | 53 | 34 | 13 | 163 | 190 | 85 | 181 | 245 | 229 |
| Endoplasmic Reticulum | 2 | 1 | 0 | 0 | 0 | 0 | 0 | 0 | 0 | 0 | 0 | 0 | 0 | 1 | 2 | 5 | 3 | 3 | 0 | 0 | 2 | 5 | 6 | 4 |
| Endosome | 1 | 0 | 0 | 0 | 0 | 0 | 0 | 0 | 1 | 0 | 0 | 1 | 2 | 2 | 2 | 4 | 0 | 1 | 7 | 2 | 0 | 4 | 1 | 3 |
| Golgi | 0 | 1 | 0 | 0 | 0 | 0 | 0 | 0 | 0 | 0 | 0 | 0 | 0 | 0 | 0 | 2 | 0 | 0 | 0 | 1 | 0 | 2 | 5 | 1 |
| Mitochondria | 19 | 6 | 0 | 9 | 2 | 17 | 25 | 21 | 51 | 70 | 72 | 57 | 17 | 7 | 4 | 2 | 4 | 0 | 12 | 9 | 6 | 22 | 22 | 13 |
| Nucleus | 59 | 34 | 9 | 7 | 4 | 2 | 5 | 5 | 8 | 13 | 5 | 6 | 31 | 15 | 0 | 1 | 0 | 1 | 69 | 37 | 13 | 11 | 6 | 17 |
| Nuclear Periphery | 1 | 1 | 0 | 0 | 0 | 0 | 0 | 0 | 0 | 0 | 0 | 0 | 0 | 1 | 0 | 0 | 0 | 0 | 0 | 0 | 0 | 0 | 1 | 0 |
| Nucleolus | 0 | 0 | 0 | 0 | 0 | 0 | 0 | 2 | 0 | 1 | 2 | 0 | 1 | 0 | 0 | 0 | 0 | 0 | 0 | 2 | 0 | 0 | 0 | 0 |
| Peroxisomes | 0 | 0 | 0 | 0 | 0 | 0 | 0 | 0 | 0 | 0 | 0 | 0 | 0 | 0 | 2 | 0 | 0 | 0 | 0 | 0 | 0 | 0 | 0 | 1 |
| SpindlePole | 1 | 0 | 1 | 0 | 0 | 0 | 2 | 1 | 0 | 3 | 1 | 1 | 0 | 0 | 1 | 1 | 2 | 0 | 28 | 18 | 4 | 5 | 7 | 11 |
| Vac/Vac Membrane | 41 | 29 | 9 | 0 | 2 | 1 | 2 | 2 | 3 | 3 | 2 | 5 | 38 | 39 | 11 | 6 | 2 | 1 | 27 | 22 | 13 | 42 | 40 | 62 |
| Unique Cell Count | 323 | 304 | 141 | 63 | 152 | 94 | 209 | 148 | 162 | 189 | 193 | 169 | 440 | 472 | 561 | 64 | 39 | 16 | 353 | 319 | 142 | 325 | 372 | 400 |
| Labelled Cell Count | 352 | 326 | 150 | 70 | 155 | 104 | 231 | 168 | 197 | 231 | 240 | 206 | 462 | 496 | 572 | 76 | 45 | 20 | 353 | 319 | 142 | 325 | 372 | 400 |
Yeast GFP Assignment
Protein Abundance
| Screen | WT1 | WT2 | WT3 | RAP60 | RAP140 | RAP220 | RAP300 | RAP380 | RAP460 | RAP540 | RAP620 | RAP700 | HU80 | HU120 | HU160 | rpd3Δ_1 | rpd3Δ_2 | rpd3Δ_3 | AF100 | AF140 | AF180 |
|---|---|---|---|---|---|---|---|---|---|---|---|---|---|---|---|---|---|---|---|---|---|
| Mean Cell GFP Intensity (1e-4) | 4.4 | 4.2 | 5.1 | 4.1 | 4.8 | 3.6 | 4.0 | 4.0 | 3.4 | 3.2 | 2.9 | 3.4 | 4.2 | 4.2 | 4.2 | 5.9 | 5.5 | 5.5 | 4.9 | 4.9 | 5.0 |
| Std Deviation (1e-4) | 0.9 | 1.0 | 1.6 | 1.2 | 1.6 | 1.7 | 1.5 | 1.3 | 1.2 | 1.2 | 0.8 | 1.3 | 1.1 | 1.5 | 1.3 | 1.7 | 1.7 | 1.5 | 1.7 | 1.3 | 1.3 |
| Intensity Change (Log2) | – | – | – | -0.32 | -0.11 | -0.53 | -0.37 | -0.35 | -0.6 | -0.69 | -0.81 | -0.58 | -0.3 | -0.29 | -0.29 | 0.21 | 0.1 | 0.1 | -0.07 | -0.07 | -0.02 |
Localization Change
| Localization | RAP60 | RAP140 | RAP220 | RAP300 | RAP380 | RAP460 | RAP540 | RAP620 | RAP700 | HU80 | HU120 | HU160 | rpd3Δ_1 | rpd3Δ_2 | rpd3Δ_3 |
|---|---|---|---|---|---|---|---|---|---|---|---|---|---|---|---|
| Actin | – | – | – | – | – | – | – | – | – | – | – | – | – | – | – |
| Bud | – | – | – | – | – | – | – | – | – | – | – | – | – | – | – |
| Bud Neck | – | – | – | – | – | – | – | – | – | – | – | – | – | – | – |
| Bud Site | – | – | – | – | – | – | – | – | – | – | – | – | – | – | – |
| Cell Periphery | – | – | – | – | – | – | – | – | – | – | – | – | – | – | – |
| Cyto | – | – | – | – | – | – | – | – | – | – | – | – | – | – | – |
| Endoplasmic Reticulum | – | – | – | – | – | – | – | – | – | – | – | – | – | – | – |
| Endosome | – | – | – | – | – | – | – | – | – | – | – | – | – | – | – |
| Golgi | – | – | – | – | – | – | – | – | – | – | – | – | – | – | – |
| Mitochondria | – | – | – | – | – | – | – | – | – | – | – | – | – | – | – |
| Nuclear Periphery | – | – | – | – | – | – | – | – | – | – | – | – | – | – | – |
| Nuc | – | – | – | – | – | – | – | – | – | – | – | – | – | – | – |
| Nucleolus | – | – | – | – | – | – | – | – | – | – | – | – | – | – | – |
| Peroxisomes | – | – | – | – | – | – | – | – | – | – | – | – | – | – | – |
| SpindlePole | – | – | – | – | – | – | – | – | – | – | – | – | – | – | – |
| Vac | – | – | – | – | – | – | – | – | – | – | – | – | – | – | – |
| Cortical Patches | – | – | – | – | – | – | – | – | – | – | – | – | – | – | – |
| Cytoplasm | – | – | – | – | – | – | – | – | – | – | – | – | – | – | – |
| Nucleus | – | – | – | – | – | – | – | – | – | – | – | – | – | – | – |
| Vacuole | – | – | – | – | – | – | – | – | – | – | – | – | – | – | – |
External localization resources
Images






























Protein Concentration and Protein Localization Data
| R1 | R2 | R3 | ||||||||||||||||
|---|---|---|---|---|---|---|---|---|---|---|---|---|---|---|---|---|---|---|
| G1 Pre-START | G1 Post-START | S/G2 | Metaphase | Anaphase | Telophase | G1 Pre-START | G1 Post-START | S/G2 | Metaphase | Anaphase | Telophase | G1 Pre-START | G1 Post-START | S/G2 | Metaphase | Anaphase | Telophase | |
| Concentration | 3.6151 | 2.5469 | 1.8802 | 1.2839 | 1.7906 | 2.6886 | 1.7273 | 0.7061 | 0.1326 | -0.0519 | -0.5404 | 0.7519 | 1.3347 | 0.1146 | -0.3964 | -0.22 | -0.6986 | 0.4621 |
| Actin | 0.0003 | 0.0005 | 0.0005 | 0.0002 | 0.0004 | 0.0006 | 0.0004 | 0.0007 | 0.0013 | 0.0004 | 0.0009 | 0.0011 | 0.0002 | 0.0007 | 0.0008 | 0.0006 | 0.0005 | 0.0009 |
| Bud | 0.0007 | 0.002 | 0.0031 | 0.0026 | 0.0064 | 0.0009 | 0.0023 | 0.0136 | 0.0081 | 0.0006 | 0.0099 | 0.0011 | 0.0011 | 0.005 | 0.005 | 0.0038 | 0.0017 | 0.0012 |
| Bud Neck | 0.0008 | 0.001 | 0.0013 | 0.0012 | 0.0024 | 0.0059 | 0.0013 | 0.0014 | 0.0026 | 0.0005 | 0.0033 | 0.0066 | 0.0009 | 0.0012 | 0.0016 | 0.0009 | 0.0012 | 0.0046 |
| Bud Periphery | 0.001 | 0.0014 | 0.0027 | 0.0028 | 0.011 | 0.0012 | 0.0022 | 0.0043 | 0.008 | 0.0006 | 0.0118 | 0.001 | 0.0008 | 0.0027 | 0.0045 | 0.0037 | 0.0017 | 0.0011 |
| Bud Site | 0.0013 | 0.0062 | 0.0027 | 0.0016 | 0.002 | 0.0008 | 0.0074 | 0.0177 | 0.0123 | 0.0002 | 0.0029 | 0.0006 | 0.0011 | 0.0082 | 0.0048 | 0.0011 | 0.0006 | 0.0003 |
| Cell Periphery | 0.0002 | 0.0002 | 0.0002 | 0.0001 | 0.0004 | 0.0001 | 0.0003 | 0.0004 | 0.0004 | 0 | 0.0003 | 0.0001 | 0.0001 | 0.0002 | 0.0002 | 0.0001 | 0.0001 | 0.0001 |
| Cytoplasm | 0.263 | 0.2262 | 0.1358 | 0.0906 | 0.1274 | 0.2162 | 0.2729 | 0.3012 | 0.2645 | 0.2805 | 0.2291 | 0.2613 | 0.2363 | 0.1944 | 0.1608 | 0.1824 | 0.2022 | 0.212 |
| Cytoplasmic Foci | 0.0038 | 0.0042 | 0.0056 | 0.0038 | 0.0066 | 0.0068 | 0.0051 | 0.0047 | 0.0101 | 0.0047 | 0.0168 | 0.0071 | 0.0034 | 0.0056 | 0.0052 | 0.0049 | 0.0063 | 0.0045 |
| Eisosomes | 0 | 0.0001 | 0.0001 | 0 | 0.0001 | 0 | 0.0001 | 0 | 0.0001 | 0 | 0.0001 | 0 | 0 | 0.0001 | 0.0001 | 0 | 0 | 0 |
| Endoplasmic Reticulum | 0.0039 | 0.0034 | 0.0023 | 0.0006 | 0.003 | 0.002 | 0.0028 | 0.0043 | 0.0036 | 0.0024 | 0.0036 | 0.0027 | 0.0026 | 0.003 | 0.0022 | 0.0029 | 0.003 | 0.0018 |
| Endosome | 0.0018 | 0.0018 | 0.0017 | 0.0006 | 0.0034 | 0.0021 | 0.0025 | 0.0034 | 0.0034 | 0.0024 | 0.0045 | 0.0028 | 0.0017 | 0.0025 | 0.0018 | 0.0026 | 0.0035 | 0.0021 |
| Golgi | 0.0001 | 0.0001 | 0.0001 | 0 | 0.0001 | 0.0003 | 0.0001 | 0.0002 | 0.0003 | 0.0001 | 0.0003 | 0.0001 | 0.0001 | 0.0002 | 0.0001 | 0.0001 | 0.0001 | 0.0001 |
| Lipid Particles | 0.0002 | 0.0001 | 0.0003 | 0.0002 | 0.0003 | 0.0002 | 0.0003 | 0.0001 | 0.0003 | 0.0001 | 0.0005 | 0.0001 | 0.0002 | 0.0002 | 0.0002 | 0.0002 | 0.0005 | 0.0001 |
| Mitochondria | 0.0006 | 0.001 | 0.0012 | 0.0007 | 0.0015 | 0.0008 | 0.0005 | 0.0017 | 0.0019 | 0.0011 | 0.0019 | 0.0008 | 0.0005 | 0.001 | 0.0011 | 0.0014 | 0.0013 | 0.0006 |
| None | 0.2781 | 0.4697 | 0.6892 | 0.8328 | 0.6906 | 0.3413 | 0.2066 | 0.3134 | 0.4842 | 0.5685 | 0.4919 | 0.2198 | 0.2879 | 0.4581 | 0.6321 | 0.5752 | 0.5893 | 0.3461 |
| Nuclear Periphery | 0.0075 | 0.0143 | 0.0041 | 0.0014 | 0.0054 | 0.0053 | 0.0083 | 0.009 | 0.0081 | 0.0074 | 0.0099 | 0.0081 | 0.0087 | 0.0079 | 0.0069 | 0.0102 | 0.0137 | 0.0065 |
| Nucleolus | 0.0025 | 0.0035 | 0.0041 | 0.0023 | 0.005 | 0.0041 | 0.0023 | 0.0059 | 0.0041 | 0.0011 | 0.0049 | 0.0037 | 0.0016 | 0.0035 | 0.0036 | 0.0034 | 0.0058 | 0.0034 |
| Nucleus | 0.4226 | 0.2545 | 0.1331 | 0.0519 | 0.1116 | 0.386 | 0.4681 | 0.2971 | 0.163 | 0.1207 | 0.1747 | 0.4473 | 0.4371 | 0.2807 | 0.1495 | 0.1852 | 0.1453 | 0.3852 |
| Peroxisomes | 0.0001 | 0.0002 | 0.0003 | 0.0002 | 0.0005 | 0.0004 | 0.0001 | 0.0003 | 0.0006 | 0.0003 | 0.0012 | 0.0003 | 0.0001 | 0.0006 | 0.0003 | 0.0004 | 0.0004 | 0.0002 |
| Punctate Nuclear | 0.0078 | 0.0062 | 0.0087 | 0.0049 | 0.0093 | 0.023 | 0.0123 | 0.0156 | 0.0168 | 0.0057 | 0.021 | 0.0327 | 0.0124 | 0.02 | 0.0159 | 0.0166 | 0.0184 | 0.0275 |
| Vacuole | 0.0034 | 0.0028 | 0.0027 | 0.0011 | 0.011 | 0.0017 | 0.0035 | 0.0044 | 0.0054 | 0.0021 | 0.0088 | 0.0024 | 0.0027 | 0.0037 | 0.0029 | 0.0035 | 0.0036 | 0.0015 |
| Vacuole Periphery | 0.0004 | 0.0005 | 0.0004 | 0.0002 | 0.0015 | 0.0003 | 0.0004 | 0.0006 | 0.0008 | 0.0005 | 0.0016 | 0.0004 | 0.0004 | 0.0005 | 0.0005 | 0.0007 | 0.0009 | 0.0003 |
Sequencing Data
| R1 | R2 | |||||||||
|---|---|---|---|---|---|---|---|---|---|---|
| G1 Post-START | S/G2 | Metaphase | Anaphase | Telophase | G1 Post-START | S/G2 | Metaphase | Anaphase | Telophase | |
| Gene Expression | 5.0899 | 5.5392 | 42.5714 | 85.4723 | 22.6671 | 7.9624 | 7.801 | 16.0654 | 47.7086 | 23.5309 |
| Translational Efficiency | 0.4033 | 0.5872 | 0.7103 | 0.6567 | 0.6339 | 0.4172 | 0.5944 | 0.6214 | 0.738 | 0.7544 |
Hit Data
| Dataset | Hit |
|---|---|
| Protein Concentration | ✔ |
| Protein Localization | ✘ |
| Gene Expression | ✔ |
| Translational Efficiency | ✔ |
Endocytosis
| Temp | Actin Patch (Sac6-tdTomato) | Cortical Patch (Sla1-GFP) | Late Endosome (Snf7-GFP) | Vacuole (Vph1-GFP) |
|---|---|---|---|---|
| 37℃ | ||||
| RT |
Cell Cycle Omics
CYCLoPs (Far1-GFP)
| Gene / Allele | Actin Patch (Sac6-tdTomato) | Cortical Patch (Sla1-GFP) | Late Endosome (Snf7-GFP) | Vacuole (Sac6-tdTomato) |
|---|
| Gene | Images |
|---|
| Gene | Images |
|---|
Images are not yet available
Images are not yet available